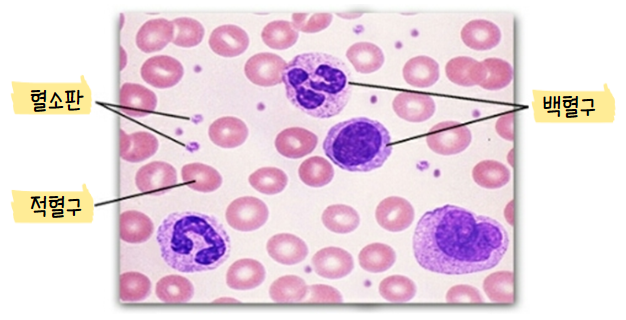

빈혈
의뢰로 주위에 빈혈을 앓고 있는 사람들이 많다. 그 정도의 차이지만 빈혈도 계속 방치하지 않는게 좋다.
간단하게 빈혈에 대해서 이야기 해보려 한다.
빈혈이란 말초 액 중에 헤모글로빈 농도가 김소한 상태를 말한다. 여기에서 헤모글로빈은 혈액의 적혈구에 있으며 산소와 결합하여 산소를 운반하는 단백질이다. 곧 헤모글로빈이 부족해지면 혈액의 산소 운반 기능이 저하된다고 볼 수 있다.
▣ 산소 + 헤모글로빈 분자 => 옥시 헤모글로빈을 형성하면서 동맥혈의 색인 밝은 빨간색이 된다.

혈액의 구성
혈액은 크게 액체인 ‘혈장’과 고체인 ‘혈구’로 이루어져 있다.
혈장은 전체 혈액의 55%를 차지하면서
대부분이 물로 구성돼 있다.
나트륨, 칼륨과 같은 전해질, 그리고 당분,
지방질과 같은 영양분을 우리 몸 전체로
운반하고 체온을 조절한다.
한편 혈구는 다시
백혈구, 혈소판, 적혈구로 나뉜다.
▷ 적혈구
주로 골수에서 만들어지며 세포와 혈액의 붉은색을 담당하는 철을 함유한 단백질 분자인 헤모글로빈이 풍부하며 산소를 운반하는 역할을 한다.
▷ 백혈구
일정한 모양이 없어 수시로 그 모양이 변하며, 불규칙한 모양의 핵을 가지고 있다. 적혈구보다 크기가 크며, 수는 적혈구보다 훨씬 적다. 백혈구는 우리 몸에 침입한 세균이나 이물질을 잡아먹는 식균 작용을 한다. 세균에 감염되면 그 수가 늘어나는 등 몸의 상태에 따라 수가 변하므로 병의 진단에 이용할 수 있다.
▷ 혈소판
지혈과 혈액의 응고에 필수적인 역할을 한다. 최근 들어 혈소판의 새로운 기능이 제시되고 있다. 대표적으로 면역기능이다. 선천면역에 관여하는 다양한 수용체가 혈소판에 발현된다는 것이 보고되었다.
▶ 즉, 백혈구는 외부에서 침입한 세균을 잡아먹고, 혈소판은 상처가 났을 때 피가 멎도록 도우며, 적혈구는 온몸에 산소를 운반하는 일을 한다.
빈혈 증상
피로, 불쾌감, 일반화 된 약점, 창백한 피부, 차가운 손과 발, 현기증, 면역력 감소, 호흡 곤란
빈혈 수치

예방
일반적인 빈혈 예방을 위해서는 균형 잡힌 식사를 통해 충분한 영양소를 공급하는 것이 중요합니다. 특히 적혈구를 만드는 데 필요한 철분과 비타민 B군, 엽산 등이 많이 함유된 식품을 섭취합니다. 철분과 엽산이 많은 식품으로는 시금치 등 녹색잎채소, 땅콩 등 견과류, 달걀, 콩류, 말린 과일 등이 있습니다. 또 비타민B와 철분 섭취를 돕는 비타민C도 섭취합니다. 비타민 보충제 등을 복용하는 것도 방법입니다.
▣ 지인에게 소개 받은 추천 영양제 : 아이언 플릭 플러스, 더블엑스, 아세로라C...

'건강' 카테고리의 다른 글
| 오메가3 효능, 추천 / 새몬 오메가3 / 오메가3 밸런스 / 뉴트리키즈 오메가3 젤리 (0) | 2023.05.29 |
|---|---|
| 암웨이 간편가입하고 둘러보기 (0) | 2023.05.21 |
| 더블엑스 효능 및 영양정보 (0) | 2023.05.20 |
| 콜레스테롤 높은 이유, 낮추는 방법, 추천 음식 (0) | 2023.05.14 |
댓글